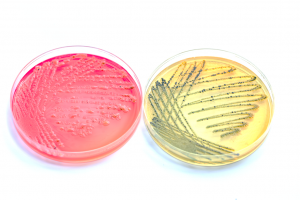
BARF gefährlich

Kategorie-Archive: Mythen
BARF-Mythen bei Welpenfütterung
BARF wird immer populärer und je mehr Leute sich damit befassen, desto mehr wird natürlich [...]
19 Kommentare
BARF – eine Gefahr für die Menschheit?
Kritiker von Rohfütterungsmethoden führen immer wieder ins Feld, wie gefährlich BARF sei, weil das rohe [...]
6 Kommentare
Barfer, sag wie hältst Du´s mit der Religion?
Ein Vorwurf, den sich Barfer häufig anhören müssen, ist, die Unterstellung, man würde diese Form [...]
BARF Mythos #5: BARF ist zu kompliziert und zu zeitaufwendig
Beim Thema Hundefütterung scheiden sich die Geister. Jeder Hersteller ist der Meinung, das beste Futter [...]
3 Kommentare
BARF Mythos #4: Fleisch macht Hunde aggressiv
Beim Thema Hundefütterung scheiden sich die Geister. Jeder Hersteller ist der Meinung, das beste Futter [...]
BARF Mythos #3: Nicht alle Nährstoffe im richtigen Verhältnis
Beim Thema Hundefütterung scheiden sich die Geister. Jeder Hersteller ist der Meinung, das beste Futter [...]
2 Kommentare
BARF-Mythos #3: Rohes Fleisch macht Hunde krank
Beim Thema Hundefütterung scheiden sich die Geister. Jeder Hersteller ist der Meinung, das beste Futter [...]
18 Kommentare
BARF-Mythos #2: Barfen sei zu teuer
Es gibt eine Reihe von Mythen, die sich rund um das Thema BARF ranken, die [...]
10 Kommentare
BARF Mythos #1: zu viel Fleisch, zu viel Eiweiß
Es gibt eine Reihe von Mythen, die sich rund um das Thema BARF ranken, die [...]
60 Kommentare